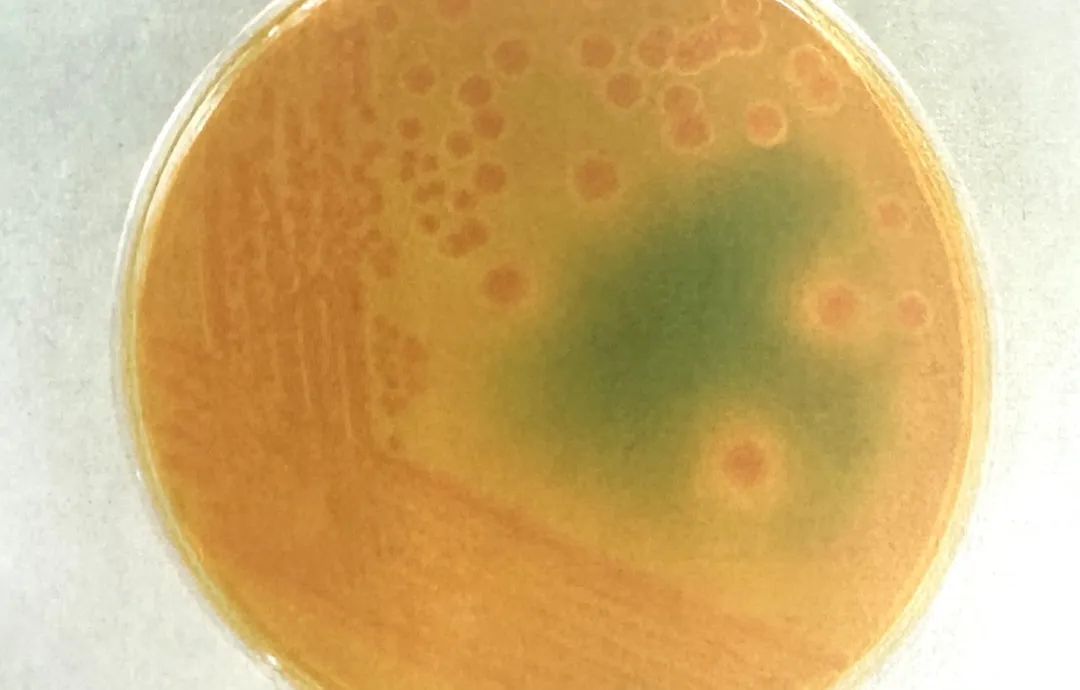
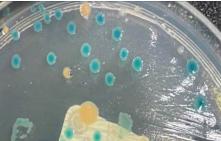

水产品在居民饮食中的占比越来越多,但在尽情享受美食的同时,需保持警惕,某些水产品处理不当会导致食物中毒和肠道感染。这些情况往往是由弧菌引起。
弧菌常年均可能引发感染,病后免疫力不强,可重复感染。霍乱弧菌和副溶性弧菌是较为熟知的致病性弧菌,但还有一些不那么常见的弧菌种类,它们同样能够引起肠道感染,严重时甚至会导致休克和死亡。

少见的致病性弧菌有哪些?
1河弧菌

河弧菌可引起散发性腹泻,在英国、美国、西班牙、非洲、中东、东南亚均有发病,各年龄组易感,但以婴幼儿和青少年多见。腹泻量较多,因此常伴失水。少数粪便带粘液或血,粪便排菌量大。2
溶藻性弧菌
溶藻性弧菌为海水中常见嗜盐性弧菌,常污染牡蛎、贝类,食用后引发剧烈腹痛、血便,易被误诊为肠胃炎。严重时可致感染性休克,儿童和老人尤其危险!3
霍利斯弧菌

霍利斯弧菌存在于海水中,患者病前大多有进食海产品史。发病以青壮年为多。腹泻症状严重,呈水样便,粘液便,少数呈血便。轻者自愈,严重者应补液纠正失水及电解质紊乱。4
创伤弧菌

创伤弧菌通常存在于海水、贝壳类海产品以及海鱼中。常在进食后24小时发病。患者大多有发热、畏寒、呕吐及腹泻的症状。除经口感染外,可经皮肤伤口入侵而发生局部感染并引起败血症,严重者发生休克并致死,病死率超过50%。肝硬化、糖尿病、免疫低下者是高危人群。5
弗尼斯弧菌
弗尼斯弧菌最初在日本及亚洲一些国家被发现,随后传播至西方国家。它可引起暴发性或散发性的急性胃肠炎。临床表现主要为腹泻和腹痛,伴有恶心和呕吐。此外,亦有严重病例导致死亡的报告。
如何预防弧菌感染?

1、水产品先煮熟再吃,醉虾、刺身风险高;2、处理海鲜戴手套,避免刺伤;
3、身上有创口时,别下水游泳或赶海;
4、高危人群要谨慎,肝病患者、长期服药者避免食用生腌、海鲜;
5、疑似感染应迅速就医,出现腹泻伴随高烧、皮肤感染快速扩散者立即就诊,并告知医生海鲜接触史!

原标题:《你知道水产里可能有这些较少见的致病性弧菌吗?》